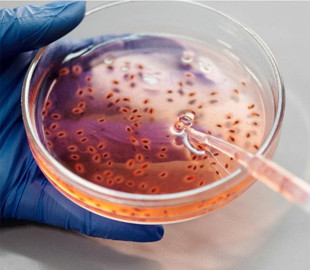
ШІ створив нові антибіотики проти супербактерій: що це за хвороби

ШІ створив нові антибіотики проти супербактерій: що це за хвороби
Штучний інтелект допоміг створити антибіотики, які можуть врятувати мільйони життів. Препарати успішно пройшли тестування у лабораторії та на тваринах.
Штучний інтелект розробив два нові потенційні антибіотики, здатні знищувати стійкі до ліків збудники гонореї та метицилін-резистентного золотистого стафілококу (МРЗС), повідомляють науковці.
Про це пише BBC.
ШІ створив ці препарати на рівні атомів, і вони успішно знищили супербактерії під час випробувань у лабораторії та на тваринах. Попри успіх, обидві сполуки ще потребують кількох років удосконалення та проходження клінічних тестів, перш ніж зможуть потрапити до медичної практики.
Дослідники з Массачусетського технологічного інституту (MТІ) вважають, що ця технологія може започаткувати «другу золоту еру» у відкритті антибіотиків. Антибіотики знищують бактерії, але резистентні інфекції щороку призводять до понад мільйона смертей у світі.
Надмірне та неконтрольоване використання таких препаратів сприяло еволюції бактерій і формуванню стійкості до лікування, а нові антибіотики з’являлися вкрай рідко протягом останніх десятиліть.
Якщо раніше штучний інтелект використовували для пошуку перспективних сполук серед відомих хімічних речовин, то тепер команда MTІ застосувала генеративний штучний інтелект для створення принципово нових молекул, орієнтованих на боротьбу з гонореєю та небезпечним МРЗС.
Як ШІ розробляв нові антибіотики?
Дослідження охопило 36 млн хімічних сполук, включно з тими, які ще не були відкриті або не існують у природі. ШІ «навчили» за допомогою даних про структуру відомих речовин і їхній вплив на ріст різних бактерій. Алгоритм опанував закономірності між молекулярними формами, що складаються з атомів вуглецю, кисню, водню та азоту, та їхнім антибактеріальним ефектом.
Було протестовано два підходи. Перший передбачав пошук перспективних фрагментів молекул розміром 8-19 атомів із подальшим конструюванням більших структур. Другий дав ШІ повну свободу у створенні молекул.Паралельно алгоритм відсіював сполуки, надто схожі на антибіотики, що вже існують, прогнозував потенційну токсичність для людини та уникав створення речовин, непридатних для медицини.
Після синтезу відібрані молекули протестували на бактеріях та заражених мишах, у результаті отримавши два нових перспективних препарати.
«Ми в захваті, адже показали, що генеративний ШІ може створювати абсолютно нові антибіотики. ШІ дозволяє швидко і недорого розробляти молекули, розширюючи наш арсенал і даючи нам перевагу в боротьбі з генами супербактерій», — зазначив професор Джеймс Коллінз із MТІ.
Коли почнуться випробування на людях?
Наразі до випробувань на людях ще далеко: для доведення безпечності та ефективності потрібно щонайменше 1-2 роки додаткових досліджень. Процес тестування є тривалим, дорогим і не гарантує, що препарат у підсумку потрапить на ринок.
Дослідники також наголошують на необхідності вдосконалення ШІ-моделей, щоб вони точніше прогнозували ефективність ліків у живому організмі, а не лише в лабораторних умовах.
Окремою проблемою залишається виробництво: зі створених алгоритмом 80 перспективних молекул проти гонореї вдалося синтезувати лише дві.
Професор Кріс Доусон з Університету Ворика назвав роботу «крутим» прикладом прогресу й зазначив, що вона є «значним кроком уперед» у застосуванні ШІ для відкриття нових антибіотиків.
Водночас він звертає увагу на економічний аспект: «Як робити ліки, що не мають комерційної вигоди?»
За словами Доусона, нові антибіотики потрібно застосовувати якомога рідше, щоб уникнути розвитку стійкості, що робить їх виробництво фінансово непривабливим.
Источник: tsn.ua




